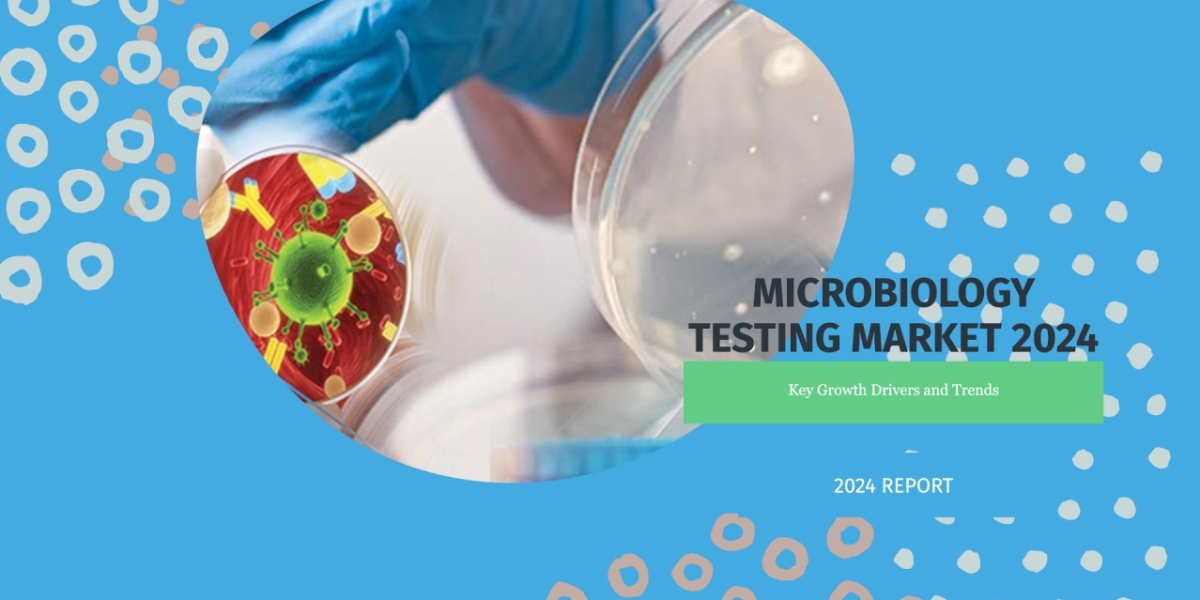
Beckman Coulter’s DxN VERIS: Transforming Pathogen Detection with Automated Molecular Diagnostics

The Role of Artificial Intelligence in Personalized Aesthetics: Key Market Trends | ##aestheticsinnovation # #healthcareinvestment # #aesthetictrends # #personalizedmedicine # #aiinhealthcare # #virtualreality # #nonsurgicaltreatments # #beautytech # #medtech # #skinhealth # #aestheticprocedures # #digitalhealth # #vrinhealthcare # #cosmeticdermatology # #healthcaretechnology # #aiinaesthetics # #minimallyinvasive # #aestheticmarket # #beautyinnovation # #medaesthetics


@NasirHussain
HCL Technologies and Siemens Healthcare: Pioneering IT and Operations Consulting in Healthcare | ##healthcareconsulting # #healthcareinnovation # #digitalhealth # #healthit # #patientcare # #consultingservices # #healthcarestrategy # #financialconsulting # #operationsconsulting # #itconsulting # #accenture # #ibm # #deloitte # #microsoft # #generalelectric # #philips # #bainandcompany # #hcltechnologies # #siemenshealthcare # #healthcaretransformation # #marketgrowth # #healthcaretrends # #consultingexperts # #healthcareproviders # #digitaltransformation # #healthinsurance # #pharmaceuticalconsulting # #medicaldeviceconsulting # #telemedicine
Amgen's Breakthrough in Calcimimetic Agents: A New Era in Chronic Kidney Disease Treatment | ##renalcare # #chronickidneydisease # #aiinhealthcare # #wearabletech # #amgeninnovation # #abbotthealthcare # #astrazeneca # #pfizermergers # #telehealth # #ckdmanagement # #kidneyhealth # #pharmar&D # #valuebasedcare # #novartis # #rochetelehealth # #gskhealthcare # #biopharma # #nephrology # #healthcareinnovation # #pharmaceuticals
Beckman Coulter’s DxN VERIS: Transforming Pathogen Detection with Automated Molecular Diagnostics | ##microbiologytesting # #ngs # #biomérieux # #beckmancoulter # #illumina # #thermofisher # #biorad # #hoffmannlaroche # #qiagen # #agilenttechnologies # #bruker # #healthcareinnovation # #infectiousdiseases # #genomics # #precisionmedicine # #clinicaldiagnostics # #foodsafety # #environmentaltesting # #medicaltechnology # #nextgensequencing
Flonase and the New Era of Intranasal Drug Delivery Systems | ##nasaldrugdelivery # #flonase # #intranasaldelivery # #pharmaceuticalinnovation # #nasalspray # #respiratorycare # #drugdeliverysystems # #healthcareinnovation # #pharmatrends # #medicaltechnology # #precisionmedicine # #patientcare # #therapeuticinnovation # #healthcaretrends # #drugformulation